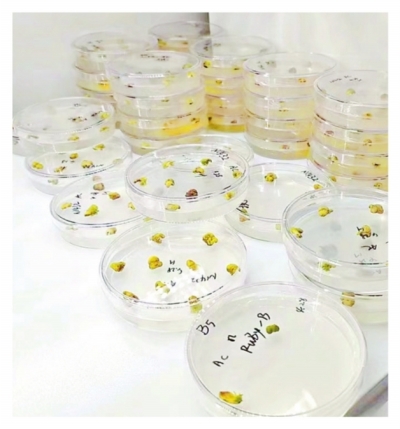

艾迪晶生物的实验室里,处于生根阶段的玉米幼苗。
何晓刚 摄

艾迪晶生物的研究人员在观察生根阶段水稻苗的生长状态。
何晓刚 摄

艾迪晶生物的研究人员在显微镜下进行大豆侵染实验操作。
何晓刚 摄

艾迪晶生物的工作人员正在进行实验操作。
艾迪晶生物的实验室里,接种到分化培养基里的植物种子。
刘晓丽 摄
“通过基因编辑技术加持,农作物的育种将能够更精准、更快速、更安全。”武汉艾迪晶生物科技有限公司(以下简称“艾迪晶生物”)副总经理邹洪锋这样介绍自己的优势和特色。
这家成立于2019年的公司,依托中国科学院院士、植物遗传学家、华南农业大学教授刘耀光及其团队先进的基因编辑技术,已经在基因育种领域初露锋芒,但邹洪锋却表示:“基因育种只是基础,未来五年,我们将在此基础上深度布局合成生物学方向。”
■ 抓住风口,二次创业进军种业
艾迪晶生物的创始人之一,公司董事长凌永国,还参与创建了光谷的另一家生物技术企业,在基因编辑技术开发及产业化方面有丰富的经验。说起创办艾迪晶生物的初衷,凌永国表示,当时他在工作中发现,越来越多的研究人员利用基因编辑技术进行育种。同时,他与刘耀光院士在工作沟通中了解到,刘耀光院士和他的团队新开发的多基因编辑技术有着广泛的应用前景。在深入了解相关领域的科研进展后,凌永国认为,基因育种以及基于此技术的合成生物学应用前景远大。于是,他和有着相同看法的刘耀光一拍即合,决定创立艾迪晶生物。
艾迪晶生物的英文名称EDGENE BIOTECH,翻译成中文就是“基因编辑生物技术”。邹洪锋解释,这表明公司的发展方向就是基因编辑技术在生物产业中的应用。凌永国认为:“基因编辑育种相较于传统育种,拥有精准高效、周期短、成本低的特点;同时,基因编辑可以帮助培育出产量更高、更有营养、更耐受极端天气、需要更少化肥和农药的作物。因此,基因编辑育种将会成为生物育种的兵家必争之技。”
那么,基因编辑育种的特色在哪里?邹洪锋介绍,生物的特性都是受基因控制的。要想消除或者添加某一个特性,传统的育种方式是通过具备不同特性的品种进行杂交,从杂交后代中挑选自己想要的新品种。这一过程周期长、盲目性大。而基因育种就比较简单明了,直接使用基因编辑工具对相应基因片段进行敲除或者替换即可。“如果把种子的基因组比作一句话,基因编辑就像是对这句话当中的某些词汇进行精简、润色等修饰,并不引入新的基因,不属于转基因范畴。”凌永国举例说,乙烯是一种易引发水果成熟的特殊气体激素,通过编辑香蕉的乙烯合成基因,可以使香蕉采后的乙烯释放量降低90%,让香蕉的储藏期从22天延长到80多天。
艾迪晶生物创立后不久,基因编辑和基因育种方面的利好信息就不断出现。其中,2022年1月,农业农村部为规范农业用基因编辑植物安全性评价工作,制定了《农业用基因编辑植物安全评价指南(试行)》,该指南的出台打破了之前我国基因编辑技术“研究领先、管理滞后、应用空白”局面。业内专家认为,新政出台标志着我国基因编辑育种技术将“有章可循”,这一行业也将进入产业化快车道,因此,2022年又被业界称为“中国生物育种元年”。
但是,和其他高新技术领域一样,核心技术是基因编辑育种的关键壁垒。“基因编辑育种包括四个部分:基因编辑工具酶、特定基因片段、底盘品种和遗传转化递送体系。”邹洪锋介绍,“这其中,基因编辑工具酶是最核心的部分,是基因编辑的芯片。目前广泛使用的CRISPR/Cas9工具酶的产权都掌握在国外。此外,基因递送体系也是非常重要的技术,每个公司都有自己的‘绝活’。”刘耀光及其团队开发的CRISPR/CasEDG-01工具酶,正是具备自主知识产权的“基因剪刀”,这也是艾迪晶生物独有的优势之一。
此外,多点基因编辑技术是刘耀光团队的“独门绝技”。“常规的基因编辑一次只能编辑一个点位,好一点的也就3-5个点位,但我们的技术可以一次性编辑最多20个点位。”凌永国对此非常自豪,“这就意味着我们能够一次实现多个特性的编辑,效率更高,这在未来的合成生物学上具有非常广阔的应用前景。”目前新的工具酶已经提交专利申请。
有着凌永国及其团队在基因编辑领域丰富的工作经验,加上刘耀光团队独有的技术加持,艾迪晶生物很快受到市场认可,与众多研究机构和种业公司建立合作。投资者们也纷纷对该公司表示关注。2022年,该公司获得数千万元的天使轮融资。
■ 布局长远,充分发挥技术优势
目前,艾迪晶生物的主要业务包括两大板块,一个是基因编辑技术服务,另一个则是种业开发与推广。其中,技术服务板块是该公司从成立之初就开展的业务,服务形式主要有两种:为种业公司、育种单位提供种业合同研究服务;与高校、研究院所合作开展功能基因研究。其中,前者需要完成合作方给出的品种特性目标,拿出最终产品;而后者则是按照科研人员的要求,对具体功能基因进行操作。
邹洪锋表示,目前艾迪晶生物的技术服务业务中,和科研人员的合作更多,增加趋势明显。为什么科研人员不自己完成基因编辑的具体工作?邹洪锋认为,艾迪晶生物的技术服务具备时间和成本优势,“科研人员自己完成具体操作,需要配齐整套的仪器设备和实验原料,如果是高校的研究生,还需要学习具体的操作技术和流程,无论时间成本还是硬件成本都太高”。
凌永国认为,基因编辑工具的精准性和高效性、可开发品种的广泛性以及项目交付的时效性,是艾迪晶生物的竞争优势。也正是因为这些优势,成立仅5年的公司,已经成为基因编辑技术服务领域的头部企业。
不过,艾迪晶生物的布局更为长远。2023年,该公司收购了山东劲豆种业有限公司,正式进军种业领域。目前兼任劲豆种业董事长的邹洪锋认为,基因编辑技术服务的市场比较单一、规模有限,要想充分发挥基因编辑技术的经济效益,就必须把产业链向后端延伸。艾迪晶生物目前已着手自己进行育种和销售,并将此作为近期的发展方向。劲豆种业作为该公司第一个种业转化平台,拥有十余个独占经营权的大豆品种,同时还将与艾迪晶生物对现有品种做进一步的编辑优化。此外,该公司今年成立了全资子公司迪晶种业,布局水稻、油菜、小麦等其他品种。据统计,艾迪晶生物今年在种业板块的收入达到4000万元,发展势头良好。
邹洪锋介绍,基因编辑农作物种子要想上市销售,需要经过安全评价和品种审定两道关卡。目前我国基因编辑植物安全评价指南已经发布,而品种审定的规则也正在制定中,一旦发布,将会为基因编辑农作物上市扫清最后的障碍。为此,国内诸多种业企业都在进行前期布局和准备,艾迪晶生物也不例外。截至目前,我国已有5个基因编辑生物安全证书获批,涉及大豆、玉米、小麦三个农作物,艾迪晶生物已有多个基因编辑的种子新品种正在申报安全评价,还有一批新品种已做好技术储备,随时可以启动申报。同时,该公司已在湖北鄂州、海南三亚、云南西双版纳等地建立了标准化的种苗种植基地,为进一步拓展育种业务打下基础。
而艾迪晶生物的长远布局还远不止于此。据了解,经过多年相关工作的积累,该公司在基因库+检测分析平台中储存了大量的基因数据和品种数据,目前已拥有水稻基因一千多个,玉米功效基因五六百个。如何充分发挥自己在基因编辑技术方面的优势,结合AI,把这些基因用起来,组合出具有不同特性的产品,是艾迪晶生物未来重要的发展方向之一。
邹洪锋举了个例子:“未来我们甚至有可能根据客户的要求,实现订单化的生产。比如食品加工企业需要某一个口味的产品,我们就能利用基因编辑技术制造出具备相应特性的种子,然后再与农户或者种植企业合作,收获产品后再交付给客户,实现全链条的打造,从而让新技术的效益得到最大化的体现。”
艾迪晶首席运营官汪杰表示:“目前,国内企业在植物基因编辑技术的研发和应用方面已处于领先水平。我们将持续攻关,围绕这项技术开拓更多的应用场景,为国家粮食安全、生产加工所需及消费市场所盼提供更多选择。”
…… 链接 ……
武汉多重优势吸引农科创企业落户
在采访中了解到,艾迪晶生物的两位主要创始人凌永国和刘耀光都不是湖北人,刘耀光院士的工作平台和研究团队更是主要在广州。那么,为什么在创立艾迪晶生物的时候会想到落户武汉?凌永国表示,这是由于武汉的综合优势所决定的。
作为高技术企业,艾迪晶生物对于技术性人才的需求量非常大。武汉高校林立,其中包括多个985、211名校,生物相关领域教育资源丰富,高水平人才储备量大。正是因为如此良好的基础,艾迪晶生物才得以在短短几年内发展到110余人,其中研究人员占比超过30%,并且研究人员都拥有硕士以上学历。此外,武汉地区高校和科研院所众多,也为初创时期的艾迪晶生物提供了大量的业务。“刚创立的时候,我们在种业方面的布局和技术储备还没有展开,但科研平台的建设又需要大量的投入,正是这些科研方面的基因编辑技术服务业务,让公司得以完成前期的积累。”凌永国对此记忆深刻。
武汉的区位优势也有额外的加分。艾迪晶生物的技术服务客户并不局限于本地,而在种业方面的拓展更需要天南海北地跑。“有时我们一年下来,出差的时间比在家里还多。”邹洪锋颇为感慨,“武汉到哪里都很方便,这对于我们开展工作、拓展业务帮助很大。”
来自政府部门的支持同样至关重要。“我们现在办公所在的高农生物园提供了房租减免、优秀人才推荐等支持,对初创企业来说非常重要。”此外,近两年艾迪晶生物承担了基因编辑抗除草剂水稻新品种培育、绿色农药分子设计等多个国家及省市种业重点项目,公司也获得了政府的专项支持。
政府部门还积极帮助企业加强沟通,寻找新的商机。2024年,武汉国家农创中心重点打造“农创芯动力”创新发展系列专题沙龙,首场活动便聚焦“基因编辑育种的技术创新与产业化”。据介绍,组织此类交流活动的基本初衷,是在交流中寻找到合作、投资的契机,加速现有领域研究成果的转化。
目前,艾迪晶生物已入选武汉“种子独角兽”企业、湖北省科创“新物种”瞪羚企业和省级上市后备“银种子”企业。“这些称号既是对我们的肯定和支持,也是对我们的激励和鞭策。”凌永国说,“在生物育种的关键卡点技术上,武汉已经具备极强的先发科研优势。我们将继续努力,助力武汉成为全国乃至全球育种研发的高地和聚集地。”
本版撰文/宋涛